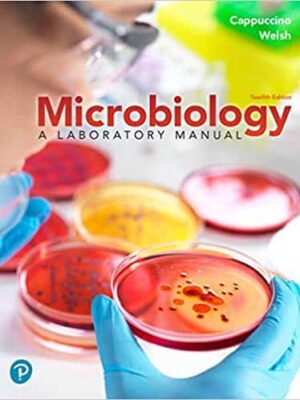
Microbiology: A Laboratory Manual (12th Edition) – eBook PDF

Bio
-
Jawetz Melnick & Adelbergs Medical Microbiology (28th Edition) – eBook PDF
Original price was: $71.24.$14.00Current price is: $14.00.Add to carteBook details
- Authors: Karen C. Carroll, Janet S. Butel, Stephen A. Morse
- File Size: 97 MB
- Format: PDF
- Length: 880 pages
- Publisher: McGraw-Hill Education / Medical; 28th edition
- Publication Date: August 25, 2019
- Language: English
- ASIN: B07RJ42Q2B
- ISBN-10: 1260012026
- ISBN-13: 9781260012026
-
Mechanobiology: From Molecular Sensing to Disease – eBook PDF
Original price was: $69.21.$8.00Current price is: $8.00.Add to carteBook details
- Author: Glen L. Niebur
- File Size: 23 MB
- Format: PDF
- Length: 237 pages
- Publisher: Elsevier
- Publication Date: December 1, 2019
- Language: English
- ASIN: B082G4SKCY
- ISBN-10: 0128179317
- ISBN-13: 9780128179314
-
Medical Biostatistics (4th Edition) – eBook PDF
Original price was: $156.00.$20.00Current price is: $20.00.Add to carteBook details
- Authors: Abhaya Indrayan, Rajeev Malhotra
- File Size: 27 MB
- Format: PDF
- Length: 720 Pages
- Publisher: Chapman and Hall/CRC; 4th edition
- Publication Date: November 27, 2017
- Language: English
- ASIN: B08R174XZF
- ISBN-10: 1498799531, 135158555X
- ISBN-13: 9781498799539, 9781498799546
- Authors: Abhaya Indrayan, Rajeev Malhotra
-
Microbiology: A Laboratory Manual (12th Edition) – eBook PDF
Original price was: $49.99.$10.00Current price is: $10.00.Add to cartFor courses in Microbiology Lab and Nursing and Allied Health Microbiology Lab.
eBook details
- Authors: James G. Cappuccino, Chad T. Welsh
- File Size: 43 MB
- Format: PDF
- Length: 560 pages
- Publisher: Pearson; 12th edition
- Publication Date: March 19, 2019
- Language: English
- ASIN: B07R4C41QZ
- ISBN-10: 0135188997
- ISBN-13: 9780135188996
-
Molecular Data Analysis Using R – eBook PDF
Original price was: $67.19.$8.00Current price is: $8.00.Add to carteBook details
- Authors: Casba Ortutay, Zsuzsanna Ortutay
- File Size: 6 MB
- Format: PDF
- Length: 331 pages
- Publisher: Wiley-Blackwell
- Publication Date: December 29, 2016
- Language: English
- ASIN: B01MR1DWCL
- ISBN-10: 1119165024
- ISBN-13: 9781119165026
-
Oxford Handbook of Infectious Diseases and Microbiology (2nd Edition) – eBook PDF
Original price was: $47.39.$6.99Current price is: $6.99.Add to carteBook details
- Authors: M. Estée Török (Estee Torok), Ed Moran, Fiona J. Cooke
- File Size: 4 MB
- Format: PDF
- Length: 912 Pages
- Publisher: OUP Oxford; 2nd edition
- Publication Date: December 6, 2016
- Language: English
- ASIN: B01N6EN0OK
- ISBN-10: 019967132X, 019105920X, 019150310X
- ISBN-13: 9780199671328, 9780191059209, 9780191503108
- Authors: M. Estée Török (Estee Torok), Ed Moran, Fiona J. Cooke
-
Solomon’s Biology (11th Edition) – eBook PDF
Original price was: $124.49.$13.00Current price is: $13.00.Add to carteBook details
- Authors: Eldra Solomon, Charles Martin, Diana W. Martin, Linda R. Berg
- File Size: 322 MB
- Format: PDF
- Length: 1408 pages
- Publisher: Cengage Learning; 11th edition
- Publication Date: January 2, 2018
- Language: English
- ASIN: B079Q81PLS
- ISBN-10: 1337392936
- ISBN-13: 9781337392938
 Campbell Biology (11th Edition) – eBook
Campbell Biology (11th Edition) – eBook